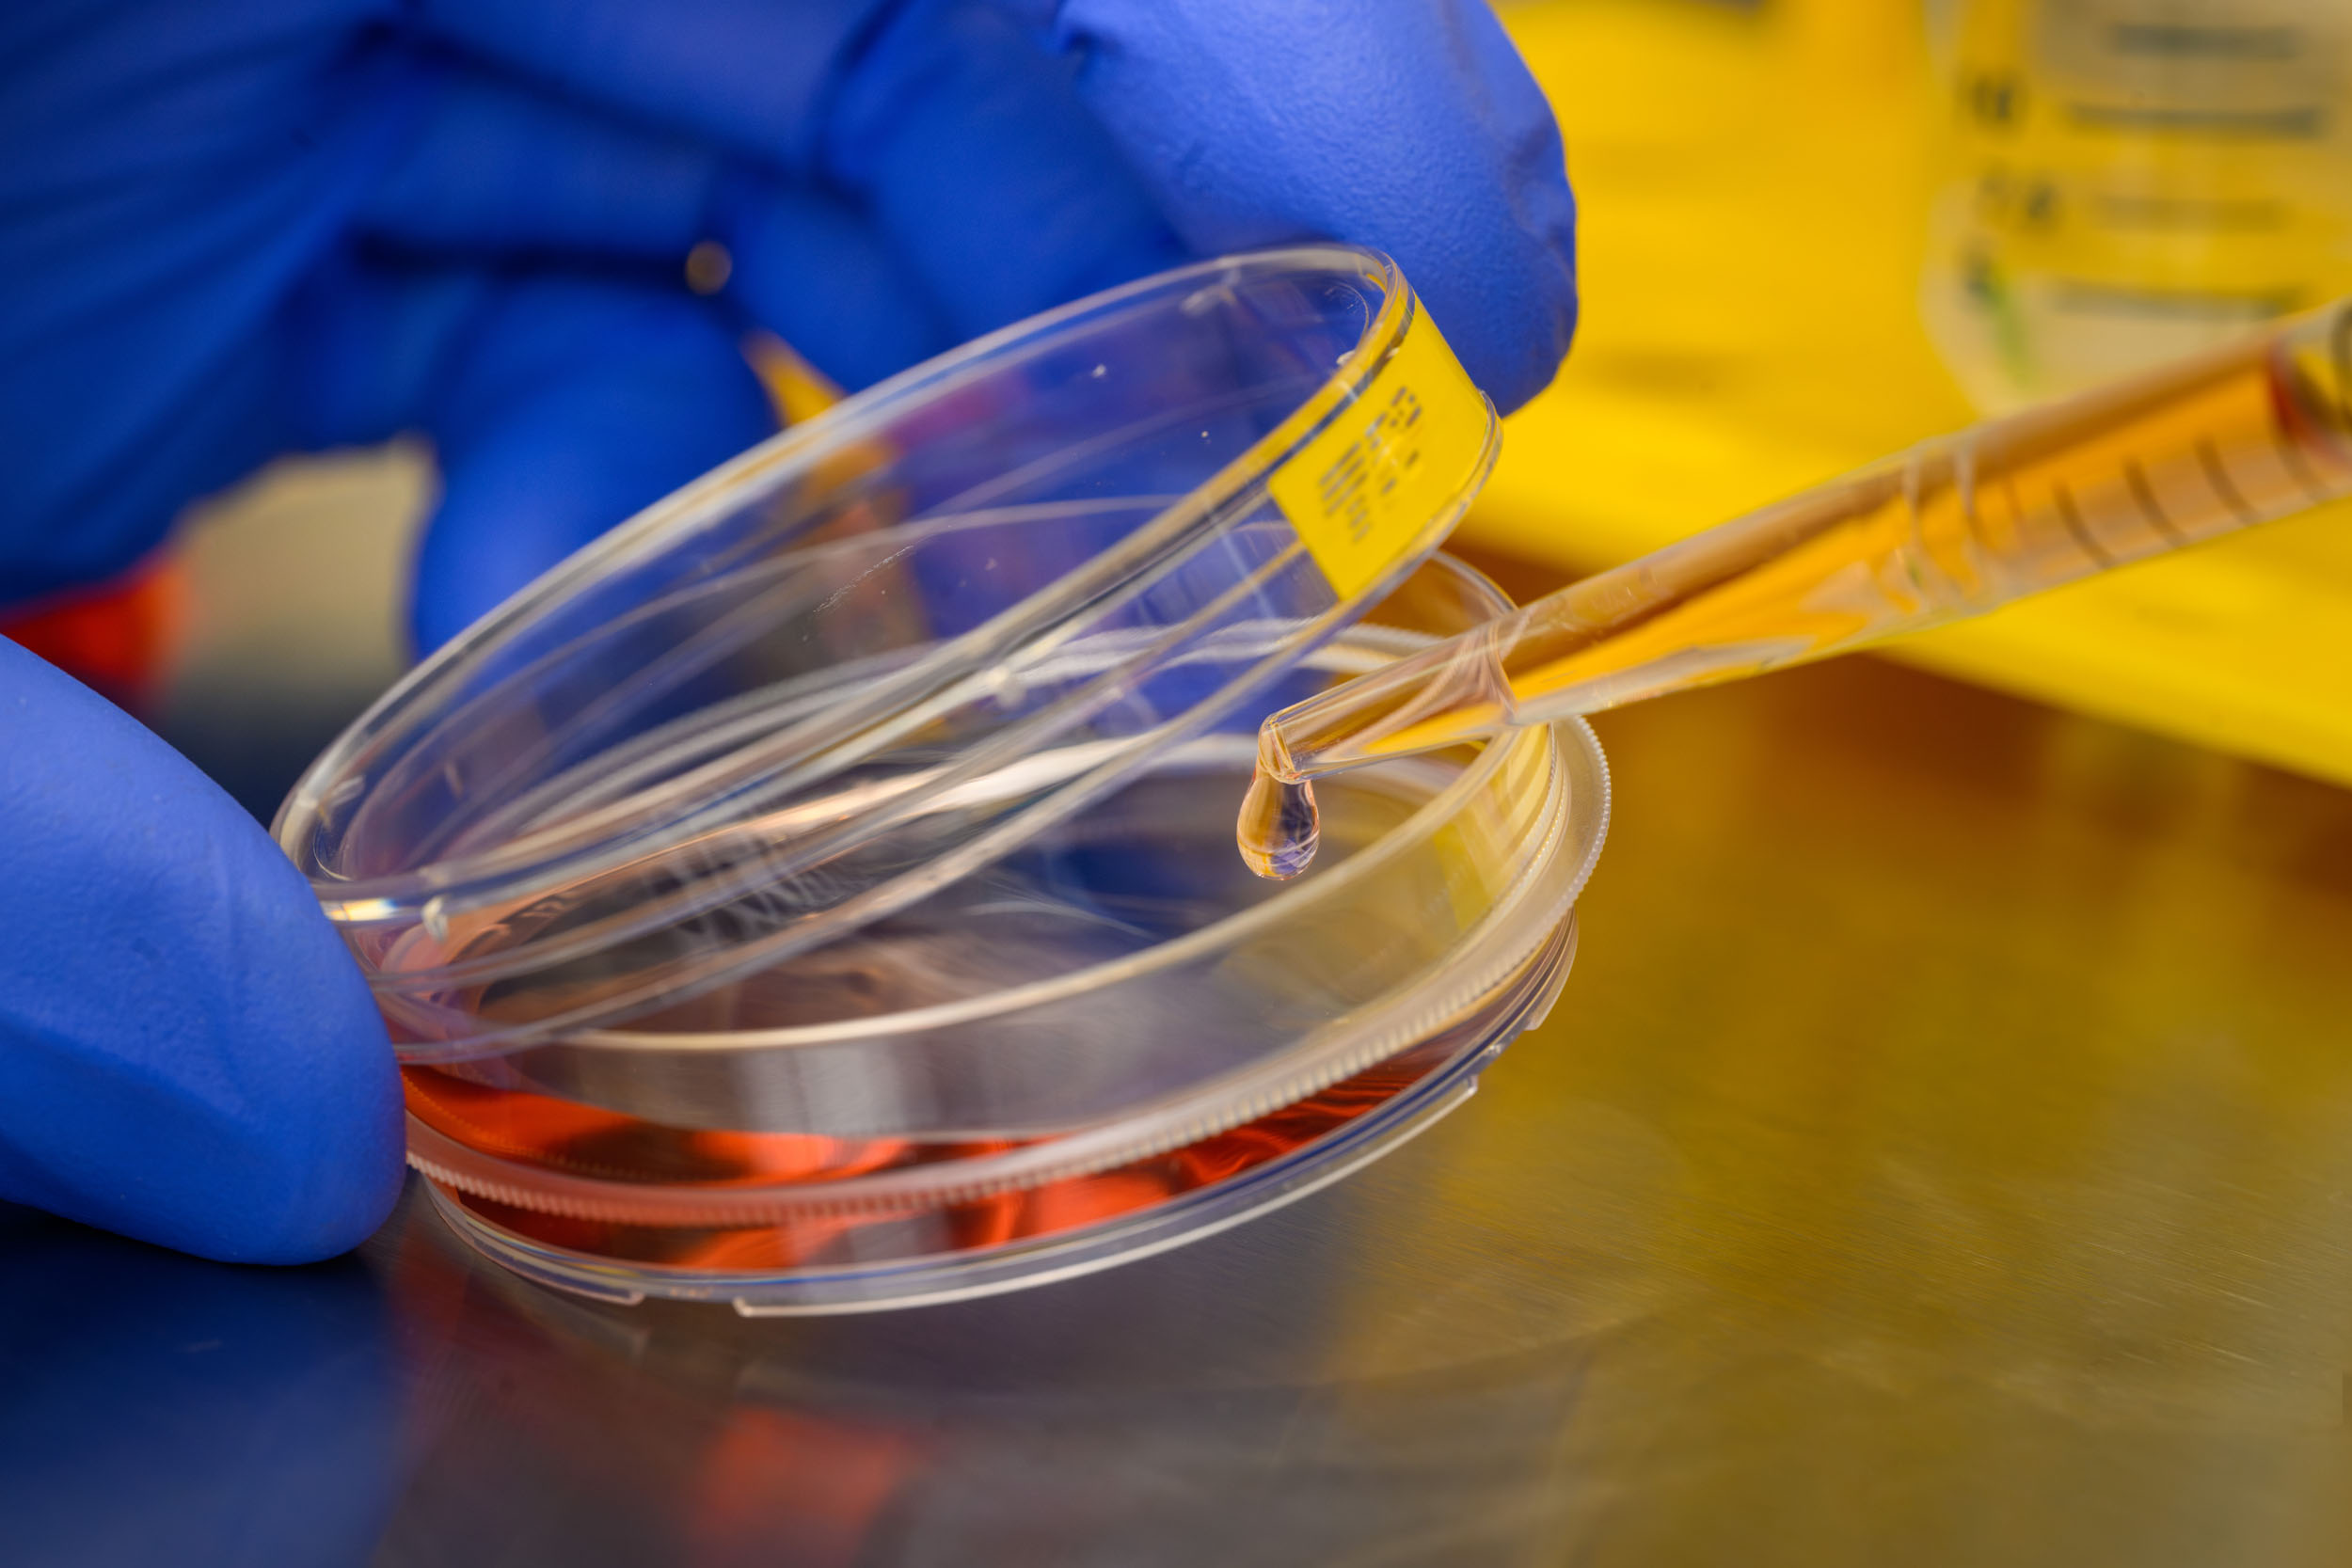

We are more than excited to announce a significant scientific advancement published in Nature Communications, resulting from the collaborative efforts of the Max Delbrück Center, the Charité – Universitätsmedizin Berlin, and the Freie Universität Berlin, with contributions from MyoPax scientists.
🔬 Research Highlights: This latest research employs mRNA-delivered CRISPR-mediated gene editing to repair a critical mutation in the dysferlin gene. The gene mutation causes dysferlin protein deficiency and leads to progressive muscle wasting and pronounced muscle weakness– in any movement everyday. This innovative approach successfully restores functional dysferlin protein and allows the formation of healthy dysferlin-expressing muscle tissue in vivo.
📚 Future Implications: This study not only demonstrates the effective and sustainable delivery of gene repair therapy for dysferlin-related muscular dystrophy using repaired patient-derived muscle stem cells but it also underscores its potential for addressing various forms of genetic muscular dystrophy.
👥 Collaborative Power: Led by Dr. Helena Escobar Fernandez and Prof. Dr. Simone Spuler, the research contributes towards effective treatments that target the root cause of the genetic disease: It stands as a testament to the profound impact that focused scientific research has on addressing pressing medical needs.
🔗 To the MDC press release: https://www.mdc-berlin.de/news/press/developing-crispr-therapy-muscular-dystrophy
🔍 To the Research Article: https://www.nature.com/articles/s41467-024-55086-0